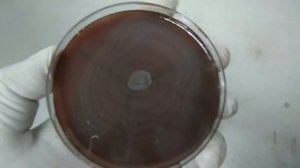
Proteus Swarming growth and its reason occuring so

1:15
1:15
2024-04-20 10:41
![Последний уикенд (2005)]() 1:26:35
1:26:35
 1:26:35
1:26:35
2023-04-01 10:15

 58:25
58:25

 58:25
58:25
2026-05-01 23:20

 1:22
1:22

 1:22
1:22
2026-01-17 17:10

 2:20:51
2:20:51

 2:20:51
2:20:51
2023-09-26 15:24

 1:31:23
1:31:23

 1:31:23
1:31:23
2025-11-26 18:00

 1:34:35
1:34:35

 1:34:35
1:34:35
2025-07-01 23:32

 29:19
29:19

 29:19
29:19
2024-03-13 18:05

 1:31:21
1:31:21

 1:31:21
1:31:21
2025-12-01 20:05

 44:05
44:05

 44:05
44:05
2024-04-29 06:24

 42:26
42:26

 42:26
42:26
2026-01-13 19:56

 1:53:32
1:53:32

 1:53:32
1:53:32
2026-03-25 10:54

 1:51:11
1:51:11

 1:51:11
1:51:11
2025-12-30 11:17

 3:50:16
3:50:16

 3:50:16
3:50:16
2024-08-19 15:47

 21:38
21:38

 21:38
21:38
2026-06-08 00:41

 1:49:31
1:49:31

 1:49:31
1:49:31
2026-06-06 10:52

 3:40:14
3:40:14
![Рустам Батербиев - Обернись (Премьера клипа 2026)]() 2:47
2:47
![SHAXO - Паранойя (Премьера клипа 2026)]() 2:22
2:22
![Жасмин - Какое счастье (Премьера клипа 2026)]() 3:35
3:35
![Misty - Летай (Премьера клипа 2026)]() 2:30
2:30
![Ислам Мальсуйгенов и Зульфия Чотчаева - Путеводная (Премьера клипа 2026)]() 3:15
3:15
![Arujan - Koz tiydime (Премьера клипа 2026)]() 3:24
3:24
![ARTIX, Анна Калайчева - Под гипнозом (Премьера клипа 2026)]() 2:29
2:29
![Гоша Грачевский - Домой (Премьера клипа 2026)]() 2:50
2:50
![Рейсан Магомедкеримов - Роза алая (Премьера клипа 2026)]() 3:52
3:52
![Группа КАРОЛИНА - Розовые краски (Премьера клипа 2026)]() 4:06
4:06
![Гоша Куценко, Юлия Пак - Твоя я (Премьера клипа 2026)]() 4:01
4:01
![Юлия Имранова - Держи меня за руку (Премьера клипа 2026)]() 3:30
3:30
![Enrasta - Адьёс (Премьера клипа 2026)]() 3:45
3:45
![Murat Gamidov - Лилия (Премьера клипа 2026)]() 2:34
2:34
![Винтаж - Малахит (Премьера клипа 2026)]() 3:44
3:44
![Ярослав Леонов - Майская роза (Премьера клипа 2026)]() 3:14
3:14
![ARTEE - Моя красивая (Премьера клипа 2026)]() 1:52
1:52
![Олег Семенов - Попутчица (Премьера клипа 2026)]() 3:00
3:00
![Дана Лахова - Найдём нашу любовь (Премьера клипа 2026)]() 2:10
2:10
![Cvetocek7 - Близкий человек (Премьера клипа 2026)]() 2:46
2:46
![Зараза | Cold Storage (2025)]() 1:39:05
1:39:05
![Они придут за тобой | They Will Kill You (2026)]() 1:35:38
1:35:38
![Хищный рывок | Thrash (2026)]() 1:26:13
1:26:13
![Трон: Арес | Tron: Ares (2025)]() 1:52:27
1:52:27
![Невеста! | The Bride! (2026)]() 2:06:44
2:06:44
![Чумовая пятница 2 | Freakier Friday (2025)]() 1:50:38
1:50:38
![Крик 7 | Scream 7 (2026)]() 1:53:59
1:53:59
![GOAT: Мечтай по-крупному | GOAT (2026)]() 1:39:46
1:39:46
![Йети | The Yeti (2026)]() 1:33:08
1:33:08
![Джек Райан: Призрачная война | Jack Ryan: Ghost War (2026)]() 1:46:53
1:46:53
![Вершина | Apex (2026)]() 1:35:30
1:35:30
![Острые козырьки: Бессмертный человек | Peaky Blinders: The Immortal Man (2026)]() 1:54:08
1:54:08
![Zомбилэнд: Контрольный выстрел | Zombieland: Double Tap (2019)]() 1:39:05
1:39:05
![Супер Марио: Галактическое кино | The Super Mario Galaxy Movie (2026)]() 1:38:18
1:38:18
![Последствия | Outcome (2026)]() 1:23:53
1:23:53
![Нормал | Normal (2025)]() 1:31:23
1:31:23
![Напоминание о нём | Reminders of Him (2026)]() 1:54:16
1:54:16
![Нескромные | Splitsville (2025)]() 1:44:43
1:44:43
![Мортал Комбат 2 | Mortal Kombat II (2026)]() 1:46:02
1:46:02
![Грозовой перевал | Wuthering Heights (2026)]() 2:16:14
2:16:14
![Папа Супергерой Сезон 1]() 4:28
4:28
![Мартышкины]() 7:10
7:10
![Пингвиненок Пороро]() 7:42
7:42
![Маугли и Акира. Новые приключения]() 11:11
11:11
![Пип и Альба Сезон 1]() 11:02
11:02
![Приключения Тайо]() 12:50
12:50
![Пластилинки]() 25:31
25:31
![Паровозик Титипо]() 13:42
13:42
![Пип и Альба. Приключения в Соленой Бухте! Сезон 1]() 11:02
11:02
![Команда Дино Сезон 2]() 12:31
12:31
![Врумиз. 1 сезон]() 13:10
13:10
![Команда Дино Сезон 1]() 12:08
12:08
![Ну, погоди! Каникулы]() 7:09
7:09
![Последний книжный магазин]() 11:20
11:20
![Чемпионы]() 7:15
7:15
![Полли Покет Сезон 1]() 21:30
21:30
![Супер Дино]() 12:41
12:41
![Сборники «Зебра в клеточку»]() 45:30
45:30
![Богатырята]() 11:00
11:00
![Панда и петушок Лука]() 12:12
12:12
![🚀 ТОП Музыка 2026: Хиты на Все Времена! 🎵 Твои Любимые Исполнители 💎]() 2:48:18
2:48:18
![MAUR - Полетела (Премьера клипа 2025)]() 2:53
2:53
![50 клипов шансона]() 3:12:53
3:12:53
![Три Кота | Сборник домашних приключений | Мультфильмы для детей]() 45:14
45:14
![Сборник На Кухне | Уральские Пельмени]() 1:30:27
1:30:27
![Аватар: Путь воды (2022)]() 3:12:39
3:12:39
![КОРОЛЬ и ШУТ /Сборник видеоклипов/]() 51:49
51:49
![Сборник Топ 20 Номеров за 2024 год - Уральские Пельмени]() 2:52:30
2:52:30
![_*ДискотекА 80-90х ВиДео АлЬбом Лучшие.*_]() 2:40:60
2:40:60
![28 лет спустя: Часть II. Храм костей | 28 Years Later: The Bone Temple (2026)]() 1:49:24
1:49:24
![Дьявол носит Prada | The Devil Wears Prada (2006)]() 1:49:29
1:49:29
![Форсаж 6 | Furious 6 (2013)]() 2:11:07
2:11:07
![Лучшие в Аду (2022)]() 1:49:08
1:49:08
![Домовёнок Кузя]() 1:29:32
1:29:32
![ANNA ASTI - ЦАРИЦА ( Премьера клипа 2023 )]() 4:01
4:01
![Рыцарь семи королевств. Все серии]() 3:28:06
3:28:06
![Клипы 90-х. Русский сборник хитов]() 1:29:27
1:29:27
![Алдан (2025)]() 1:38:04
1:38:04
![Jazzdauren - Дарите женщинам цветы]() 3:09
3:09
![Ми–Ми–Мишки 💫 Звездная история 🙃 Все серии ✨ Мультики для детей]() 2:10:31
2:10:31

 3:40:14
3:40:14Скачать Видео с Рутуба по ссылке
| 192x144 | ||
| 480x360 | ||
| 640x480 |
 2:47
2:47
2026-05-26 11:05
 2:22
2:22
2026-04-28 11:11
 3:35
3:35
2026-05-16 13:07
 2:30
2:30
2026-06-02 13:00
 3:15
3:15
2026-05-30 11:43
 3:24
3:24
2026-05-16 13:20
 2:29
2:29
2026-04-28 10:53
 2:50
2:50
2026-06-04 09:50
 3:52
3:52
2026-05-09 18:11
 4:06
4:06
2026-05-24 15:36
 4:01
4:01
2026-05-21 11:24
 3:30
3:30
2026-05-26 11:32
 3:45
3:45
2026-04-29 14:24
 2:34
2:34
2026-04-29 11:20
 3:44
3:44
2026-04-28 12:53
 3:14
3:14
2026-05-02 00:31
 1:52
1:52
2026-06-04 09:59
 3:00
3:00
2026-05-26 11:26
 2:10
2:10
2026-05-12 12:35
 2:46
2:46
2026-05-24 15:25
0/0
 1:39:05
1:39:05
2026-05-07 15:06
 1:35:38
1:35:38
2026-05-20 08:37
 1:26:13
1:26:13
2026-04-29 20:33
 1:52:27
1:52:27
2026-05-20 08:38
 2:06:44
2:06:44
2026-04-22 11:21
 1:50:38
1:50:38
2026-05-20 08:38
 1:53:59
1:53:59
2026-04-22 11:21
 1:39:46
1:39:46
2026-06-01 17:19
 1:33:08
1:33:08
2026-04-15 12:24
 1:46:53
1:46:53
2026-05-26 12:53
 1:35:30
1:35:30
2026-04-30 16:00
 1:54:08
1:54:08
2026-03-21 11:57
 1:39:05
1:39:05
2026-06-01 17:20
 1:38:18
1:38:18
2026-05-12 16:55
 1:23:53
1:23:53
2026-04-17 14:43
 1:31:23
1:31:23
2026-05-27 11:57
 1:54:16
1:54:16
2026-05-28 20:15
 1:44:43
1:44:43
2026-04-09 22:40
 1:46:02
1:46:02
2026-05-18 11:14
 2:16:14
2:16:14
2026-04-20 11:54
0/0
2021-09-22 21:52
 7:10
7:10
2025-12-30 18:33
 7:42
7:42
2024-12-17 12:21
2026-06-04 14:09
2021-09-22 23:37
 12:50
12:50
2024-12-17 13:25
 25:31
25:31
2022-04-01 14:30
 13:42
13:42
2024-11-28 14:12
2021-09-22 23:36
2021-09-22 22:40
2021-09-24 16:00
2021-09-22 22:29
 7:09
7:09
2026-04-11 10:00
 11:20
11:20
2025-09-12 10:05
2026-06-09 12:30
2021-09-22 23:09
 12:41
12:41
2024-11-28 12:54
 45:30
45:30
2025-12-11 18:53
 11:00
11:00
2026-04-23 16:13
 12:12
12:12
2024-11-29 14:21
0/0
 2:48:18
2:48:18
2026-04-24 09:34
 2:53
2:53
2025-04-24 09:53
2022-12-22 16:10
 45:14
45:14
2020-04-22 20:10
2025-04-04 18:26
2025-06-17 19:00
2022-09-14 19:48
2025-01-13 14:00
2024-03-18 17:25
 1:49:24
1:49:24
2026-02-19 14:08
 1:49:29
1:49:29
2023-04-27 15:40
 2:11:07
2:11:07
2023-04-25 22:52
2022-10-20 11:01
2025-03-15 20:49
 4:01
4:01
2023-10-12 11:54
 3:28:06
3:28:06
2026-02-24 11:12
2024-01-12 11:40
 1:38:04
1:38:04
2026-03-26 23:45
 3:09
3:09
2024-05-30 14:13
2024-01-17 17:34
0/0

